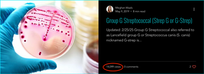

ELYSIAN BENGALS
Meghan Waals
Breed Preservationist, Mentor, Speaker, Animal Wellness Coach
Phone:
717-917-7418
Email:
Address:
Burnsville, NC
Website:
elysianbengals.com
ABOUT
Elysian Bengals was the first business I scaled from the ground up, where I built and solidified a cohesive brand presence that grew into a world-renowned name in the Bengal breeding community. I developed the cattery’s branding, marketing, digital presence, and client engagement systems while establishing credibility through industry leadership, PR, and educational initiatives. This project showcases my ability to turn a startup vision into a recognized, influential, and sustainable brand.
SERVICES AND ROLES
Branding, Marketing and Digital Presence
-
Built and operated an internationally recognized Bengal preservation cattery, establishing a premium, science-backed brand trusted across the global feline breeding industry
-
Developed complete brand architecture including brand positioning, messaging strategy, tone of voice standards, visual identity systems, and long-term brand development planning
-
Delivered Branding & Marketing Consultations to industry peers, advising on brand positioning, messaging clarity, digital presence, and customer experience strategy
-
Designed and managed full Website Design & Management processes including UX layout, SEO structure, conversion optimization, landing pages, blog integration, and ongoing content updates
-
Created and implemented comprehensive Lead Generation strategies including funnel architecture, audience targeting, educational lead magnets, conversion tracking, and data-driven refinement
-
Managed Social Media Content Creation including campaign planning, caption writing, visual design, engagement strategy, and audience growth initiatives
-
Authored Blog Writing content focused on education, authority positioning, and long-form content marketing
-
Produced complete Graphic Design assets including:
-
Logos / Icons
-
Flyers / Brochures
-
Ad Layouts
-
Infographics (data visualization)
-
Business Cards / Postcards
-
-
Designed ad campaign layouts and promotional materials for digital and print distribution
-
Created structured visual branding systems ensuring consistency across web, social, print, and presentation materials
Virtual Assistant, Administrative and Executive Support Functions
-
Performed full Virtual Assistant responsibilities within a single-operator enterprise environment
-
Managed Email Management systems including inbox organization, high-volume correspondence, template creation, and communication tracking
-
Prepared and managed contracts, onboarding documentation, client education materials, and administrative records
-
Oversaw document organization, task management systems, and workflow documentation
Lead Generation, CRM and Systems Management
-
Built and managed CRM Management systems to track client lifecycle from inquiry through application, contract execution, placement, and alumni engagement
-
Designed structured client intake systems with qualification criteria and educational filtering processes
-
Maintained client database organization, pipeline visibility, and retention metrics
-
Created community-building strategies to increase referrals, retention, and brand advocacy
Public Relations, Advocacy and Industry Leadership
-
Managed Public Relations initiatives including brand reputation management, industry communication, and strategic storytelling
-
Led an international legislative campaign advocating for updates to Bengal breed recognition standards, coordinating global stakeholders and committees
-
Built collaborative relationships with breeders, veterinarians, researchers, and international organizations
-
Partnered with Christopher Kaelin (Stanford University) contributing phenotype documentation and breeder data supporting research on the Agouti Prionailurus bengalensis (APb) gene
-
Strengthened brand authority by bridging scientific research with applied breeding practice
Budgeting, Financial Oversight and Time Management
-
Managed Budgeting processes including expense tracking, forecasting, financial planning, and cost analysis
-
Oversaw revenue strategy, pricing structure, and operational cost management
-
Implemented Time Management systems balancing breeding operations, marketing, research collaboration, client support, event planning, and administrative duties
-
Designed workflow optimization systems improving efficiency and task prioritization
Business Operations and Enterprise Management
-
Operated as a single-owner enterprise responsible for full operational management
-
Oversaw systems management including CRM integration, document workflows, and communication pipelines
-
Built scalable business systems transforming Elysian Bengals into a structured, premium enterprise rather than a hobby operation
TOOLS AND PLATFORMS
Wix, Canva, Facebook, Pinterest, Tiktok, Instagram, Lulu Printing, Vistaprint, Signwell
New: Piktochart
ASSETS
SOCIAL PROOF AND STATISTICS
Website:
-
87,700 unique visitors
-
1118.2 site sessions
-
Source
-
51,200 google (organic)
-
16,200 Direct
-
15,900 Facebook
-
-
2600 Referrals
-
Global Reach: 169+ Countries & Territories
-
1.2 M Impressions
-
20,700 Clicks
Blog
Top Blogs
-
20,400 views
-
16,700 views
-
15,000 views
Unique Visitors 67,300
Post Views 96,300
4.6K Followers
*Page Insights data is restricted to the last two years business retired in 2023, website still active